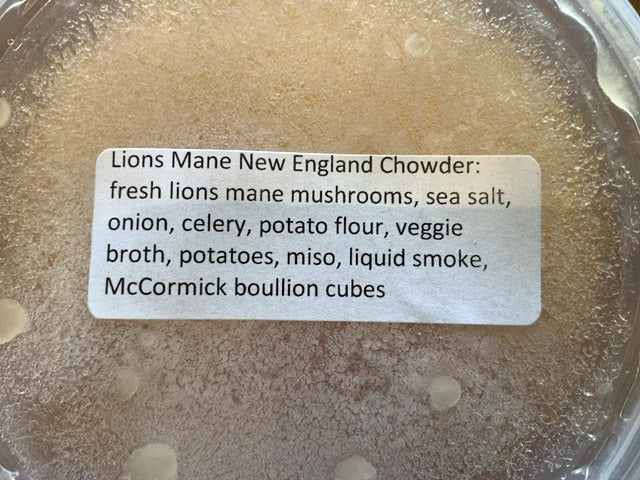

1
/
of
2
JJ's Vegan Cheese
JJ's Vegan Cheese - Soup - Lion’s Mane (large)
JJ's Vegan Cheese - Soup - Lion’s Mane (large)
Regular price
$20.00 CAD
Regular price
Sale price
$20.00 CAD
Unit price
/
per
Couldn't load pickup availability
Share